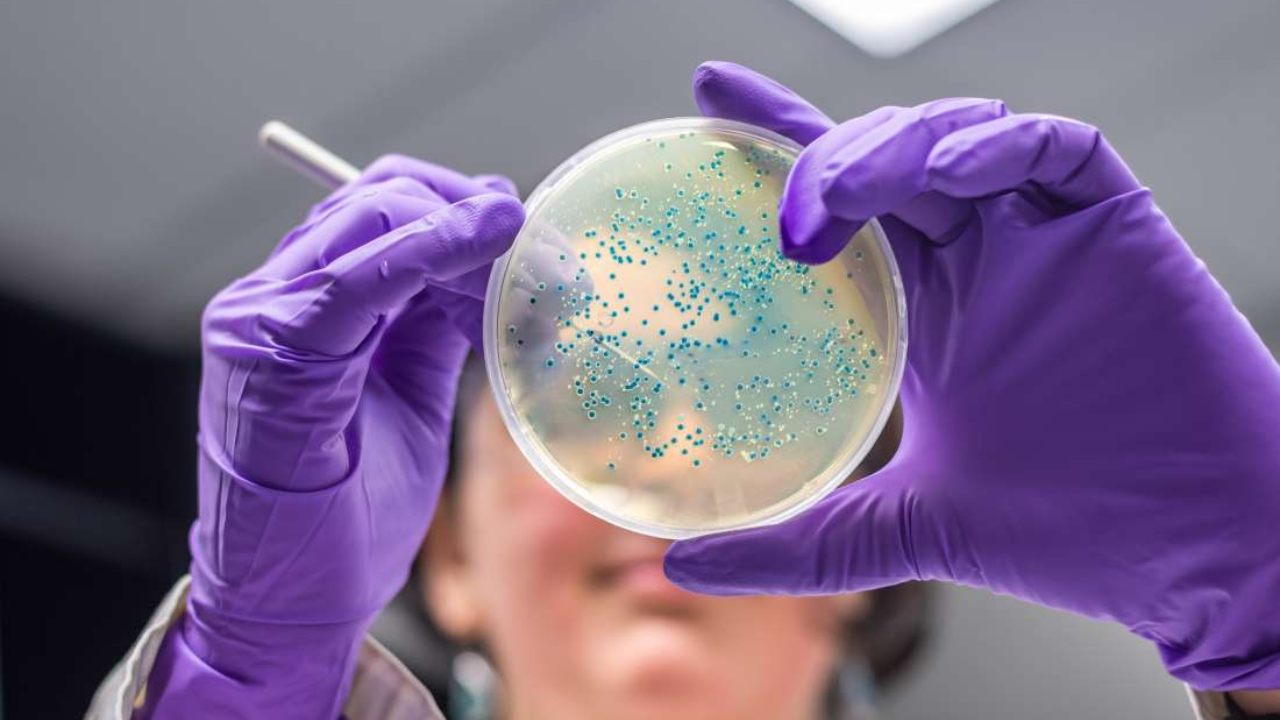
Mechanism used by bowel cancer cells to multiply decoded by scientists, in a first Mechanism used by bowel cancer cells to multiply decoded by scientists, in a first

Researchers have identified a key protein that supports the growth of many bowel cancers, an advance that may lead to new therapies against the malignant disease. The study, published in the Journal of Cell Biology, revealed that a protein called Importin-11 transported the cancer-causing protein Beta-catenin into the nucleus of bowel cancer cells, where it can drive cell proliferation. According to the scientists, including those from University of Toronto in Canada, inhibiting this transport step could block the growth of most of such cancers caused by elevated Beta-catenin levels. They said about 80 percent of these cancers are associated with mutations in a gene called APC which result in elevated levels of the Beta-catenin protein. High levels of this protein are followed by its accumulation in the cell nucleus, where it can activate numerous genes behind cell proliferation.
The scientists added that the protein also promotes the growth and maintenance of tumours in the large intestine and its concluding part, rectum. But, the researchers said, how the protein enters the cell nucleus after its levels rise is poorly understood. “Because the molecular mechanisms underlying Beta-catenin nuclear transport remain unclear, we set out to identify genes required for continuous Beta-catenin activity in colorectal cancer cells harbouring APC mutations,” said Stephane Angers, study co-author from the University of Toronto. The researchers developed a new technique using CRISPR gene editing technology to screen the human genome for genes supporting Beta-catenin’s activity in bowel cancer cells after its levels are elevated by mutations in APC. One of the genes they identified was IPO11, which codes for a protein called Importin-11. According to the researchers, Importin-11 is involved in importing proteins into the nucleus. Angers and his colleagues found that Importin-11 binds to Beta-catenin and escorts it into the nucleus of colorectal cancer cells which have mutations in APC. They said removing Importin-11 from these cells prevented Beta-catenin from entering the nucleus and activating its target genes. Importin-11 levels, the scientists said, are often elevated in human colorectal cancers, and removing this protein inhibited the growth of tumours formed by APC mutant cancer cells. “We conclude that Importin-11 is required for the growth of colorectal cancer cells,” Angers said. According to the scientists, learning more about how Importin-11 transports Beta-catenin into the nucleus may help researchers develop new therapies which block this process, and reduce the growth of colorectal cancers caused by mutations in APC.
)